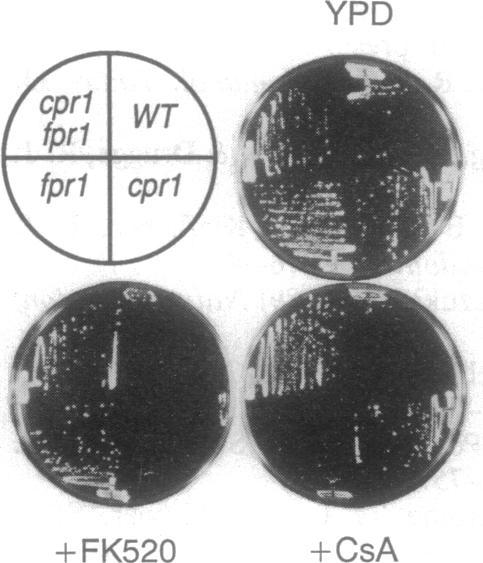
https://cdn.ncbi.nlm.nih.gov/pmc/blobs/91cd/43997/080d8a256873/pnas01134-0166-a.jpg

钙调神经磷酸酶在对环孢菌素A和FK506敏感的酵母菌株中至关重要。
Calcineurin is essential in cyclosporin A- and FK506-sensitive yeast strains.
作者信息
Breuder T, Hemenway C S, Movva N R, Cardenas M E, Heitman J
机构信息
Howard Hughes Medical Institute, Duke University Medical Center, Durham, NC 27710.
出版信息
Proc Natl Acad Sci U S A. 1994 Jun 7;91(12):5372-6. doi: 10.1073/pnas.91.12.5372.
The immunophilin-immunosuppressant complexes cyclophilin-cyclosporin A (CsA) and FKBP12-FK506 inhibit the phosphatase calcineurin to block T-cell activation. Although cyclophilin A, FKBP12, and calcineurin are highly conserved from yeast to man, none had previously been shown to be essential for viability. We find that CsA-sensitive yeast strains are FK506 hypersensitive and demonstrate that calcineurin is required for viability in these strains. Mutants lacking cyclophilin A or FKBP12 are resistant to CsA or FK506, respectively. Thus, both the immunosuppressive and the antifungal actions of CsA and FK506 result from calcineurin inhibition by immunophilin-drug complexes. In yeast strains in which calcineurin is not essential, calcineurin inhibition or mutation of calcineurin confers hypersensitivity to LiCl or NaCl, suggesting that calcineurin regulates cation transport.
免疫亲和蛋白 - 免疫抑制剂复合物亲环蛋白 - 环孢素A(CsA)和FKBP12 - FK506抑制磷酸酶钙调神经磷酸酶以阻断T细胞活化。尽管从酵母到人,亲环蛋白A、FKBP12和钙调神经磷酸酶高度保守,但此前没有一个被证明对生存力至关重要。我们发现对CsA敏感的酵母菌株对FK506超敏感,并证明钙调神经磷酸酶是这些菌株生存所必需的。缺乏亲环蛋白A或FKBP12的突变体分别对CsA或FK506有抗性。因此,CsA和FK506的免疫抑制作用和抗真菌作用均源于免疫亲和蛋白 - 药物复合物对钙调神经磷酸酶的抑制。在钙调神经磷酸酶并非必需的酵母菌株中,钙调神经磷酸酶抑制或其突变会导致对LiCl或NaCl超敏感,这表明钙调神经磷酸酶调节阳离子转运。